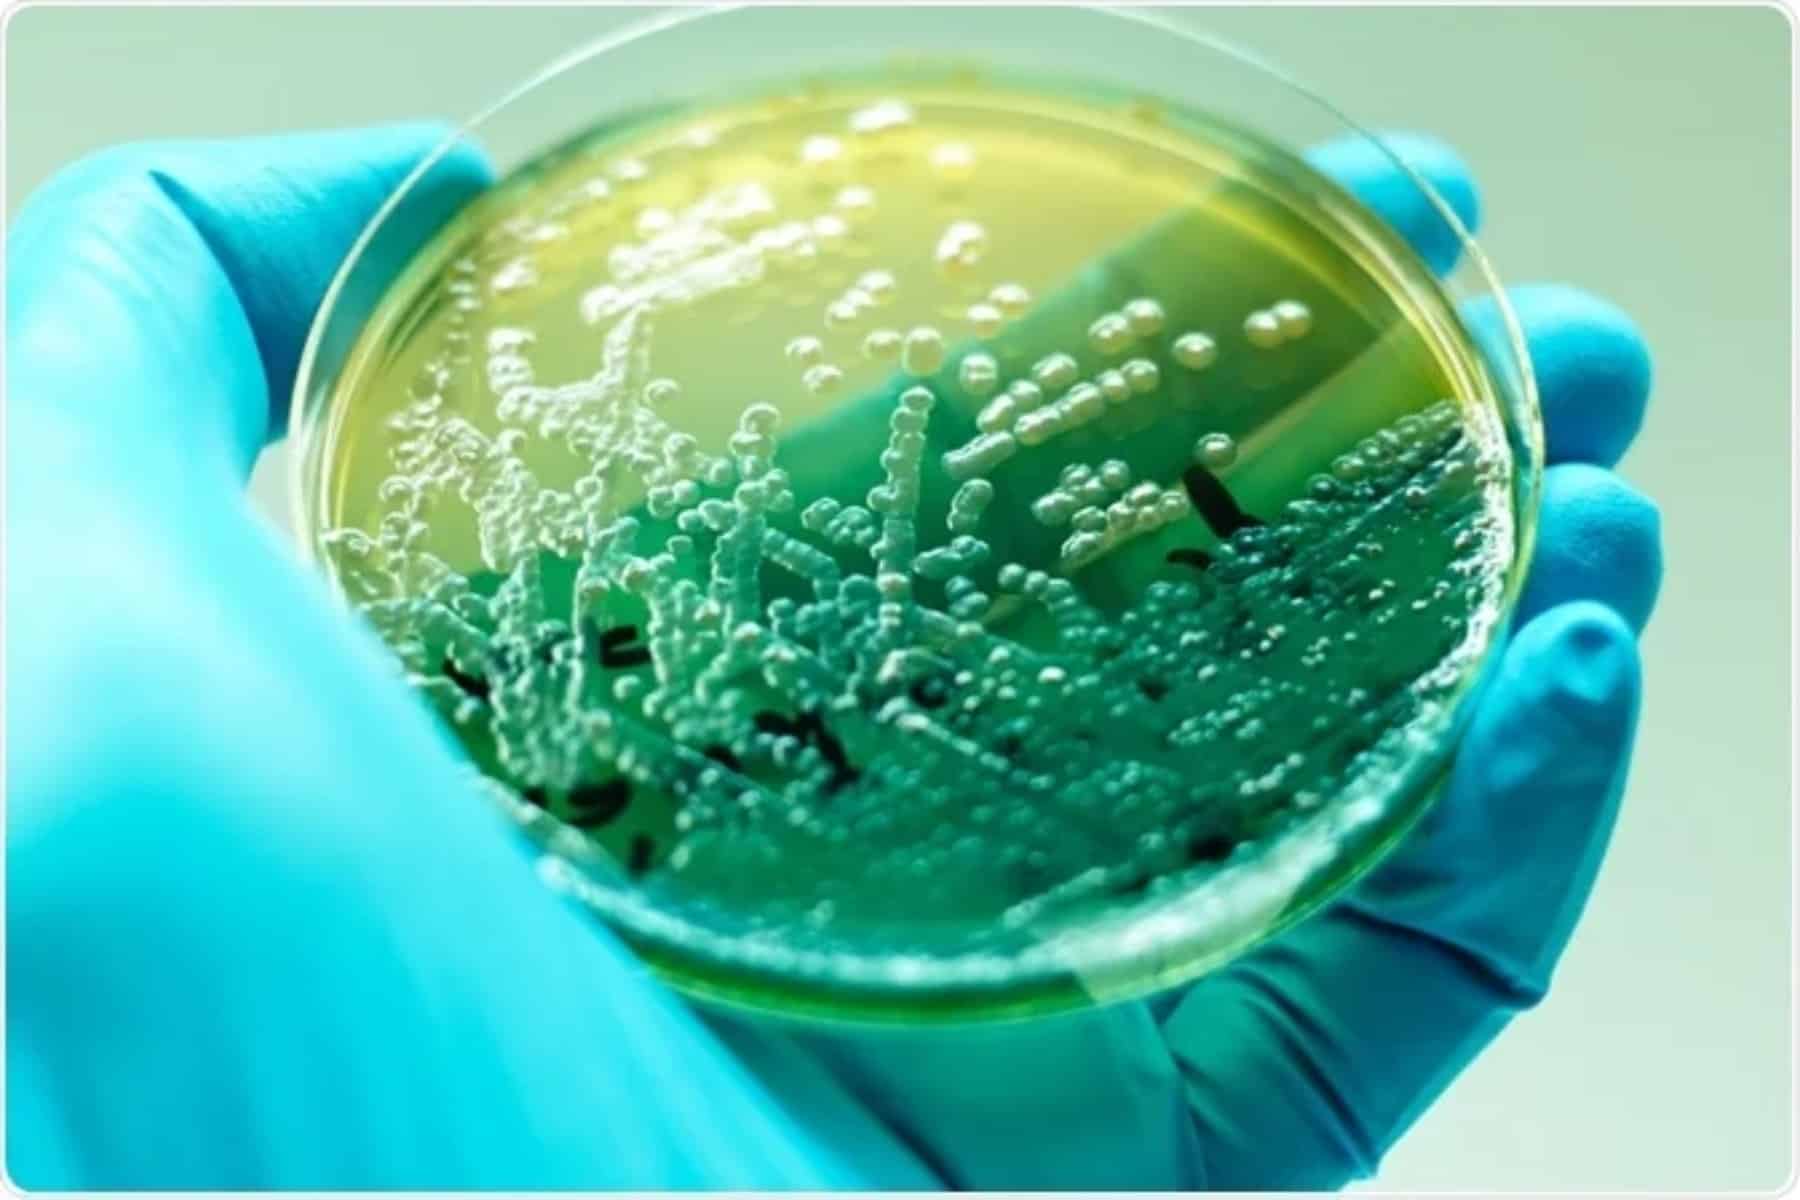

Η ψηφιακή αθανασία αποτελεί μία από τις πιο ριζοσπαστικές και αμφιλεγόμενες ιδέες της σύγχρονης τεχνολογικής σκέψης. Αυτό που μέχρι πρόσφατα ανήκε αποκλειστικά στη σφαίρα της επιστημονικής φαντασίας, σήμερα εξετάζεται σοβαρά από ερευνητές της νευροεπιστήμης, της τεχνητής νοημοσύνης και της φουτουριστικής τεχνολογίας. Η βασική υπόθεση είναι ότι η ανθρώπινη συνείδηση, δηλαδή οι σκέψεις, οι αναμνήσεις και η προσωπική ταυτότητα, θα μπορούσε να μεταφερθεί σε ένα ψηφιακό περιβάλλον, προσφέροντας μια νέα μορφή ύπαρξης πέρα από τα βιολογικά όρια.

Η θεωρητική βάση της ψηφιακής συνείδησης
Στον πυρήνα της ψηφιακής αθανασίας βρίσκεται η άποψη ότι η συνείδηση είναι αποτέλεσμα πολύπλοκων υπολογιστικών διεργασιών του εγκεφάλου. Οι νευρώνες και οι μεταξύ τους συνδέσεις δημιουργούν ένα δυναμικό δίκτυο, μέσα από το οποίο προκύπτουν η σκέψη, η μνήμη και η αυτοαντίληψη. Εάν αυτό το δίκτυο μπορούσε να χαρτογραφηθεί με απόλυτη ακρίβεια και να αναπαραχθεί ψηφιακά, τότε θεωρητικά θα μπορούσε να δημιουργηθεί ένα λειτουργικό αντίγραφο της ανθρώπινης συνείδησης. Σε αυτό το σενάριο, η ύπαρξη δεν θα εξαρτάται πλέον από το βιολογικό σώμα, αλλά από την υπολογιστική υποδομή που φιλοξενεί το ψηφιακό «εγώ».
Κονεκτωμική και χαρτογράφηση του εγκεφάλου
Ένα από τα βασικά επιστημονικά πεδία που σχετίζονται με την ψηφιακή αθανασία είναι η κονεκτωμική, δηλαδή η χαρτογράφηση όλων των νευρωνικών συνδέσεων του εγκεφάλου. Παρότι έχουν επιτευχθεί σημαντικές επιτυχίες σε απλούς οργανισμούς, ο ανθρώπινος εγκέφαλος παραμένει μια τεράστια πρόκληση. Με περίπου 100 δισεκατομμύρια νευρώνες και τρισεκατομμύρια συνδέσεις, η πλήρης καταγραφή του απαιτεί τεχνολογίες που προς το παρόν βρίσκονται πέρα από τις δυνατότητές μας. Παρ’ όλα αυτά, κάθε πρόοδος σε αυτόν τον τομέα μας φέρνει πιο κοντά στην κατανόηση της δομής της συνείδησης.
Εξομοίωση ολικού εγκεφάλου και υπολογιστικά όρια
Η εξομοίωση ολικού εγκεφάλου αποτελεί ένα ακόμη φιλόδοξο βήμα προς την ψηφιακή αθανασία. Η ιδέα περιλαμβάνει τη λεπτομερή σάρωση της δομής και της λειτουργίας του εγκεφάλου και τη δημιουργία ενός ψηφιακού μοντέλου που θα αναπαράγει τη συμπεριφορά του. Ωστόσο, οι απαιτήσεις σε δεδομένα και υπολογιστική ισχύ είναι τεράστιες. Ακόμη και τα πιο προηγμένα υπερυπολογιστικά συστήματα δυσκολεύονται να προσομοιώσουν απλές νευρωνικές διεργασίες, πόσο μάλλον την πλήρη ανθρώπινη συνείδηση.
Διεπαφές εγκεφάλου και μηχανής
Μια πιο άμεση και ρεαλιστική προσέγγιση είναι οι διεπαφές εγκεφάλου-υπολογιστή. Αυτές οι τεχνολογίες επιτρέπουν την άμεση επικοινωνία μεταξύ νευρικού συστήματος και ψηφιακών συσκευών. Σήμερα χρησιμοποιούνται κυρίως σε ιατρικές εφαρμογές, όπως η αποκατάσταση κινητικών λειτουργιών ή η αντιμετώπιση νευρολογικών παθήσεων. Μακροπρόθεσμα, όμως, θα μπορούσαν να αποτελέσουν το πρώτο βήμα για τη σταδιακή συγχώνευση της ανθρώπινης συνείδησης με ψηφιακά συστήματα.
Ηθικά και φιλοσοφικά ερωτήματα
Η προοπτική της ψηφιακής αθανασίας εγείρει βαθιά ερωτήματα για την ταυτότητα και την ανθρώπινη φύση. Εάν δημιουργηθεί ένα ψηφιακό αντίγραφο της συνείδησης, είναι αυτό το ίδιο πρόσωπο ή απλώς μια προσομοίωση; Παράλληλα, ζητήματα ιδιωτικότητας και συγκατάθεσης αποκτούν κρίσιμη σημασία, καθώς τα δεδομένα του εγκεφάλου είναι η πιο προσωπική μορφή πληροφορίας. Επιπλέον, το κόστος και η πρόσβαση σε τέτοιες τεχνολογίες ενδέχεται να εντείνουν τις κοινωνικές ανισότητες.

Το μέλλον της ψηφιακής αθανασίας
Παρότι η πλήρης ψηφιακή αθανασία απέχει ακόμη δεκαετίες, η έρευνα στον τομέα αυτό ωθεί τα όρια της γνώσης μας για τη συνείδηση και τον εγκέφαλο. Ανεξάρτητα από το αν η ανθρώπινη συνείδηση θα μπορέσει ποτέ να «μεταφορτωθεί», η εξερεύνηση αυτής της ιδέας μας αναγκάζει να επαναπροσδιορίσουμε τι σημαίνει ζωή, ταυτότητα και θνητότητα. Η ψηφιακή αθανασία δεν αποτελεί απλώς τεχνολογικό όραμα, αλλά έναν καθρέφτη των βαθύτερων ανθρώπινων επιθυμιών για συνέχεια και νόημα πέρα από τον χρόνο.